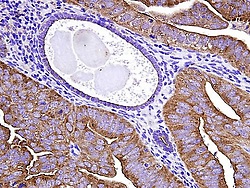

La técnica consiste en la introducción de ADN en las células instructoras del sistema inmunológico; así, el ADN dirigiría estas células para que produzcan, en exceso, una proteína específica que impulsa el desarrollo de importantes células T asesinas. Estas células asesinas suelen ser reprimidas en los pacientes con VIH, o cáncer, explica el doctor José A. Guevara-Patiño, autor principal del estudio, profesor asociado en el Instituto de Oncología de la Universidad Loyola.
El estudio se centró en las células asesinas conocidas como células T CD8 y sus células instructoras, conocidas como células presentadoras de antígenos. Las células instructoras se encargan de que las células T CD8 se conviertan en células T asesinas, destinadas a destruir células infectadas o células de cáncer, y de que permanezcan vigilantes si los patógenos reaparecen, o si el cáncer vuelve a aparecer.
Además de recibir instrucciones de las células presentadoras de antígenos, las células T CD8 necesitan la colaboración de células T ayudantes para convertirse en asesinas eficaces. Sin esta ayuda, las células T asesinas no pueden hacer su trabajo.
En los pacientes que tienen VIH, el virus destruye las células T ayudantes; y en los pacientes con cáncer, éstas células T también se ven afectadas. Entre las propiedades insidiosas de un tumor, se encuentra su capacidad para evitar que las células T asesinas los ataquen, mediante la supresión de las células T ayudantes, limitando su capacidad para ayudar a las células T CD8, según explica el doctor Andrew Zloza, uno de los autores principales del estudio.
En el estudio, se introdujeron fragmentos de ADN en las células ayudantes -mediante un dispositivo conocido como pistola de genes- para que estas células produjeran proteínas específicas, que actúan como claves moleculares. Cuando las células T CD8 interactúan con las células ayudantes, las mencionadas claves moleculares desbloquean las propiedades asesinas de las células T CD8, estimulándolas para que ataquen a los agentes patógenos y las células cancerosas.
Con el uso de esta técnica, las células T asesinas no necesitan la ayuda de las células T auxiliares, así que, incluso si un tumor suprimiera su actividad, las células T asesinas todavía serían capaces de matar a las células cancerosas.
